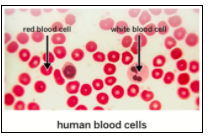

Do you think it is a waste of time to study small things? Why or why not?
Sentence Starter:
I think it (is/is not) a waste of time to study small things because...
What job was given to us by the Microbiome Research Institute?
It turns out that tiny living things are all over our body. In fact, you have 100 trillion of them on and inside of you right now, and they’re really important to keeping you alive! This leads to the question we’re going to answer in this unit:
It may seem weird and unbelievable that you have tiny living things on and in your body! Before we explore them, let’s make sure we have a few key vocabulary words under our belts:


Below are three images of a human eye; the second two are from a microscope.

Is an eyelash mite an organism, a microorganism, or both?
Sentence Starter:
An eyelash mite is (an organism/a microorganism/both) because...
How small do you think microorganisms in the human body are? (It’s okay if you aren’t sure yet; we’ll be coming back to this in a few lessons).
Sentence Starter:
I think a microorganism is smaller than a….
I think this because….
To start understanding the size of living things, we’re going to compare the sizes of a few tiny things.
Scale is the relative size of two objects; in other words, how the sizes compare.

Sort the objects from smallest to largest. Don’t worry if you get them wrong for now, we will check our answers in a bit!

A chipmunk is a(n) _______
Explain why you selected that answer!
What is an example of a microorganism you learned about today?
What is the largest organism you know about?
There are millions of tiny living things in our body called...
Together...these tiny living things form what is called...
How do you think microorganisms are important for our body?